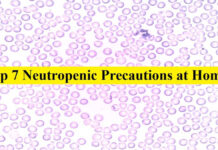
Top 7 Neutropenic Precautions at Home | Review Neutropenic Precautions review

Fever After Surgery | Causes | Symptoms | Preventions
The surgical procedure is for sure a restless experience that marks stress, anxiety, and even fever as it is after effect. Most of the patients come up...
7 Easy Ways to Fix DNS Probe Finished Bad Config Error | For Windows...
Do you operate the net regularly? Almost every young and old are using this miraculous service every moment they need to search for anything. The internet has...
A Guide to Have an Ultimate Experience at Smith’s Marketplace
Getting financial rewards from your own business is so exciting and joyful. Isn’t it? Starting your own business means you are the boss of yourself and it’s...
What is IDP.Generic? | 5 Easy Methods to Get Rid Of This Virus
Are you receiving a notification that sounds somewhat like IDP.Generic? Don’t get panic because we bring you a detailed article about what IDP.Generic is and how can...
Pivot Interactives | Learning Beyond the Boundaries
Learning has become rapidly digitalized especially after the arousal of Covid-19. Teachers, students, and educational organizations have rushed towards the digital means to spread the knowledge and...
How to Turn Off Wifi Calling? | Easy Ways to Turn Off on...
Phone calling has been a great way of communication for decades. Over time, this technology has got advanced and many new features and attributes have been introduced...
Top 7 Neutropenic Precautions at Home | Review
Neutropenia is a condition in which there are low levels of neutrophils (white blood cells). Neutrophils protect the body from infections. Without enough neutrophils, you are at...
What is Orthopedic Urgent Care? | Top 7 Benefits
Orthopedic urgent care is used design specifically for a patient with very recent sports injuries, arthritis, sprains, or fractures.
When someone experiences the pain...
What is [pii_email_37f47c404649338129d6]: 6 Simple Guidelines to This Solve Error
Many people use Microsoft outlook nowadays, as it's the third most in-demand email client in the world. The main reason for that is, other than its use...
A Comprehensive Overview of VPNs | Top 6 Benefits
The process of choosing a VPN for your online data security is one of the most important moves. Whether you are a parent, looking for a VPN...

![What is [pii_email_37f47c404649338129d6]: 6 Simple Guidelines to This Solve Error what is [pii_email_37f47c404649338129d6] ? | fixed](https://bhtnews.com/wp-content/uploads/2021/02/pii-email-37f47c404649338129d6-218x150.jpg)
